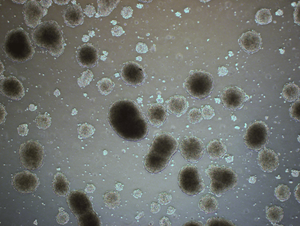

ROSES-24 Blog

The research emphases of E.9 Space Biology: Research Studies falls under two broad categories: Precision Health and Space Crops. For Precision Health-focused studies, investigators may propose to use any non-primate animal model system, and any appropriate cell/tissue culture/microphysiological system/organoid or…
The research emphases of E.9 Space Biology: Research Studies falls under two broad categories: Precision Health and Space Crops. For Precision Health-focused studies, investigators may propose to use any non-primate animal model system, and any appropriate cell/tissue culture/microphysiological system/organoid or…

F.11 Payloads and Research Investigations on the Surface of the Moon: Stand Alone Landing Site Agnostic (PRISM SALSA) solicits proposals for investigations that include development and flight of science-driven payloads to be delivered to the lunar surface by the Commercial…

A.41 SERVIR Applied Sciences Team (AST) solicited proposals for membership on the SERVIR Applied Sciences Team and Team member projects until it was paused on February 19, 2025. Earlier this month USAID notified SERVIR partners that they have terminated all…

“Research Opportunities in Space and Earth Sciences (ROSES) 2024” has several “No Due Date” (NoDD) programs with no fixed due date, for which proposals may be submitted at any time until March 28, 2025, the nominal cut-off date at the…

The Transiting Exoplanet Survey Satellite (TESS) General Investigator (GI) Program solicits proposals for the acquisition and analysis of scientific data from the TESS mission. The primary purpose of the TESS GI Program is to enhance and maximize the science return…

D.17 XRISM General Observer (GO) seeks proposals for participation in the NASA program for the conduct of space science observations using the X-ray Imaging and Spectroscopy Mission (XRISM) and for related supporting atomic physics investigations. ROSES-2024 Amendment 116 announces the…

A.41 SERVIR Applied Sciences Team (AST) solicits proposals for membership on the SERVIR Applied Sciences Team and Team member projects through this program element. The primary purpose of this Team is to improve, enrich, and expand the use of Earth…

A.65 Responsive Science Initiatives Research (RSIR) solicits scientific research required to address societal challenges in three thematic areas: Proposals must advance scientific knowledge with the intention of supporting follow-on applications for end users. In addition, investigations must: Proposals submitted to…






